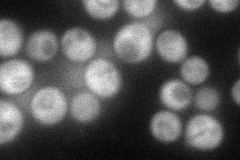
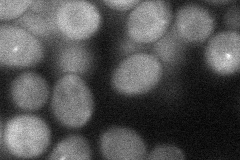
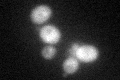
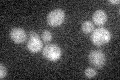

View description
Multistep regulator of cAMP-PKA signaling; inhibits PKA downstream of Gpa2p and Cyr1p, thereby increasing cAMP dependency; inhibits Ras activity through direct interactions with Ira1p/2p; regulated by G-alpha protein Gpa2p; homolog of Gpb2p
Localization:
Intensity:
Fold change:
Significance:
-
C’ GFP library in SD

cytosol28.14 -
N' NOP1pr-GFP in SD
cytosol81.1135 -
N' TEF2pr-mCherry in SD

missing0 -
N' NATIVEpr-GFP in SD

below threshold19.9626 -
N' TEF2pr-VC and Cyto-VN in SD
cytosol39.8221 -
C’ GFP library in SD+DTT
cytosol28.921.02No -
C’ GFP library in SD+H2O2

cytosol26.570.94No -
C’ GFP library in Starvation Media
cytosol23.340.82No -
C’ GFP library on the background of Pup2-DaMP

cytosol -
C’ GFP library on the background of CCT mutant

cytosol25.10930.892204No
